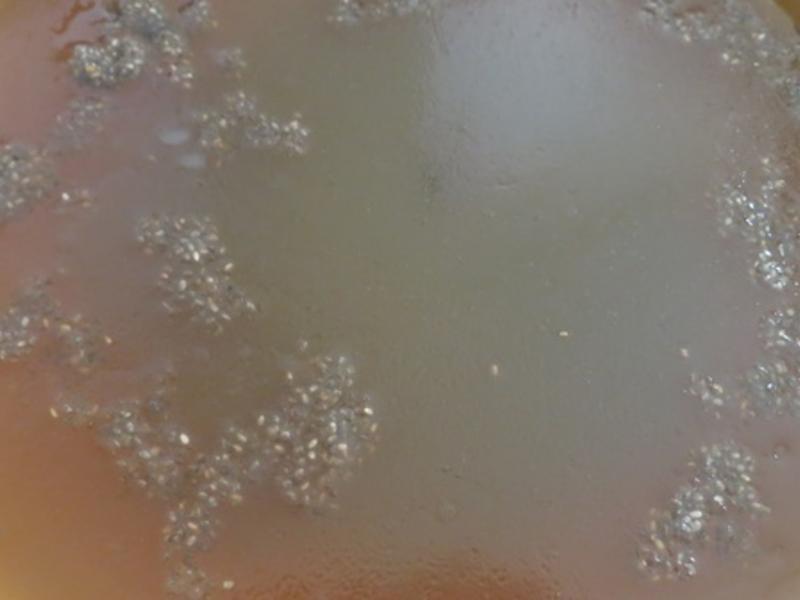
������ʯ���˶��ϲ足?!!!������

1
1准备材料
 2
2将天然的石花菜称重洗好后备用(若没有石花菜可使用洋菜粉替代)
 3
3我是使用 2 quarts 的锅子, 将 1800 ml 水滚开
 4
4将冬瓜茶块放入
 5
5搅拌均匀热溶
 6
6等水滚后,用过滤网放置洗好的石花菜, 架跨于锅上, 约煮 10-15 分 中 (也可将石花菜直接水煮,再过滤皆可)
 7
7煮到石花菜,没有澎澎得样子, 如照片
 8
8将滤网石花菜离锅
 9
9放入适量的 Chia seeds-奇亚籽
 10
10搅拌均匀
 11
11就完成简单的 Chia seeds-奇亚籽冬瓜茶石花菜
 12
12等候待凉
 13
13待凉后,放入冷藏
14
14冷藏至完全凝固便可.可依喜好加入少许牛奶品尝更佳!!
 15
15是冰冰凉凉夏日清凉消暑或饭后的最佳甜点 Chia seeds Agar Wax Gourd Jelly-奇亚籽石花菜冬瓜茶冻?!!!
 16
16Bon Appétit & Enjoy!!!
